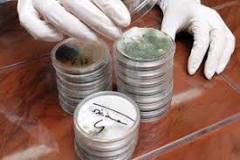

envirotech air purifier nz
The health risks of mold in the home have been well-documented and it may cause extensive property damage. Mold remediation can be an expensive process, but it is best handled sooner rather than later. Molds are a type of fungus. They grow best in warm, moist environments and they survive by digesting decaying organic materials. Because they do not use chlorophyll to produce food, molds do not need sunlight to survive. Without mold, the entire world would be overrun by dead plant matter, so it's an important part of the environment. The key to mold growth is the level of moisture in the environment. Mold will grow in any environment that is sufficiently moist that also contains any kind of food source. Common food sources for mold in the structure of the home include drywall, window frames, carpeted or uncarpeted flooring, bathroom tile, and interior insulation. Mold developing in the structural materials of a basement or crawlspace may require special attention. Mold may also develop on furniture.

Common sources of moisture that could lead to indoor mold include condensation from high humidity or large temperature differences, roof leaks, flooding, plumbing leaks, or excessive humidity. Exposure to environmental mold can lead to skin irritation, breathing difficulties, allergic reactions and headaches. Mold can be an irritant, causing a burning sensation to the skin, lungs, nose, throat or eyes. It can trigger asthma attacks in people who are allergic, and even non-allergic asthma sufferers may experience worsened symptoms because of exposure to indoor mold.
air purifier for bronchitisSymptoms of allergic reaction include sneezing, red eyes, runny nose or the appearance of skin rash.
joker machine air cleaner sportsterThe EPA reports that repeated exposure to mold can bring about sensitivity and health problems, so it is important to put an end to mold exposure as soon as possible.
airbrush cleaner createx

Molds can also produce mycotoxins, which are toxic substances that may be found either within or on the surface of mold spores. Mycotoxins can enter a person's system via ingestion, inhalation or skin contact. Aflatoxin B1 is the best-known mycotoxin; it is a potent carcinogen, the inhalation of which can cause lung cancer. It is produced by the molds Aspergillus parasiticus and Aspergillus flavus. Those who suspect an indoor growth of mold should begin by having the area tested by a professional. Many contractors offer free testing. Mold sampling should be performed by those who have specific working knowledge of sampling methods and protocols, including those recommended by the American Conference of Governmental Industrial Hygienists or the American Industrial Hygiene Association. Investigations often disturb potential areas of growth. It may be necessary, for example, to remove sections of wallpaper to examine drywall or sections of carpet to test floorboards. Either action may release mold spores into the air.

Mold inspections should:Be performed by qualified personnel, preferably a certified professional with a number of years of experience in mold removal.Examine sites of potential mold development and look for sources of moisture. Examine indoor air quality for the presence of mold spores or other irritants.Check for areas of past or current growth within interior walls, floors, ceilings and other areas where mold growth is common. There are a number of factors that can impact the cost of mold removal in any particular instance. The amount of mold and level of development can necessitate the replacement of structural materials, for example, and specialized protective and disposal equipment is often required. Small remediation projects can be performed by a property owner for a minimal cost, but larger jobs should be performed by professionals and may cost upwards of $10,000. Nationally, homeowners report an average cost for mold remediation of just over $7,500. If the mold infestation covers 100 square feet or less in total area, the EPA says that property owners can generally handle the project themselves.

For larger areas, though, mold remediation is best left to the professionals. Additionally, if mold is found in more than one area of the home, it is best to leave the cleanup work to a professional mold removal crew. Labor costs can make up a large part of the total price of mold remediation. Qualified removal companies make use of skilled labor and expensive equipment. A High Efficiency Particulate Air (HEPA) vacuum, for example, is a $10,000 piece of machinery that makes use of special filters and powerful suction to remove mold from materials. Workers operating HEPA vacuums must wear mold-proof suits and face masks and must be specially-trained. Material costs will vary widely from one project to another. In some cases, mold may have eaten away lumber, sheet rock and floor boards. In other cases, it may be present only in carpet or small areas of walls and ceilings. Thus, material costs vary from less than a hundred dollars on the low end to tens-of-thousands of dollars for the remediation of a flooded basement, for example.

Those who are attempting to take the project on themselves will probably want to rent or purchase a wet vacuum to pull moisture from carpet and wood. They can be rented for around $30 per day or can be purchased for between $80 and $200. For very small mold remediation projects, only water and detergent are required. Moisture is the key to mold growth. Fix any plumbing leaks or other sources of moisture as early on in the process as possible. Use a solution of detergent and water to scrub away mold on hard surfaces.Drywall, carpet and other porous materials are often irreparable once they are moldy. Throw away and replace these materials.Wear gloves and goggles and use a respirator to avoid breathing airborne mold. An N-95 respirator, available at most hardware stores for between $12 and $25, is recommended for those performing mold remediation.Remediation is done when all of the mold is completely removed. There should be no visible mold and no odor of mold. After cleanup, the site or sites should not show signs of moisture accumulation or mold growth.